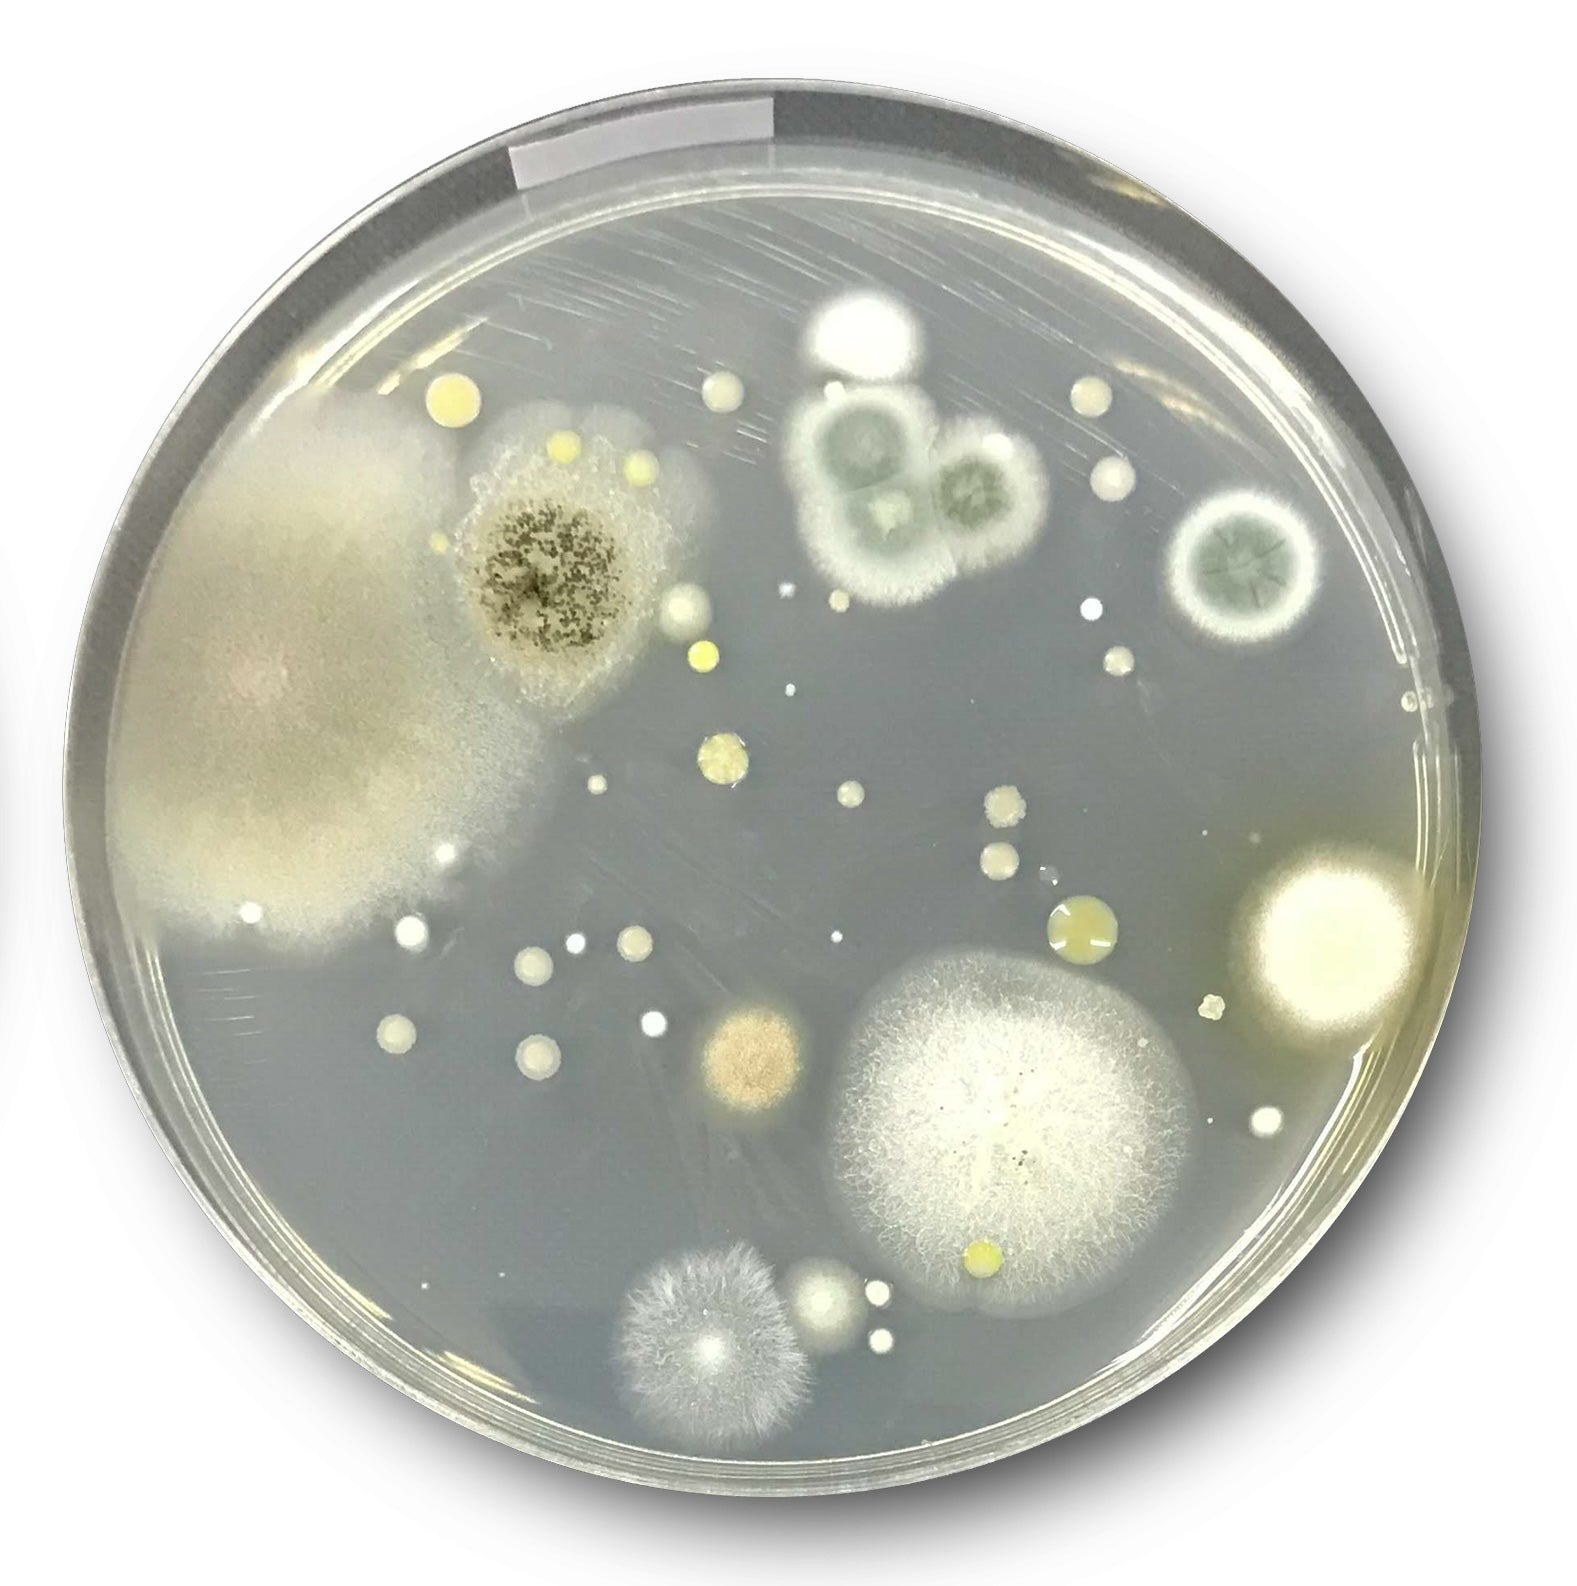
Before Image

Clean and Safe Product Delivery with Lunaescent Touch-Free Skincare Applicator
No Fingers. No Germs. Just Product.
Touch-free tool for hygienic and effective application
Clinical Results
100%
0%
100%
0%

Frequently Asked Questions
What are the benefits of using Lunaescent Touch-Free Skincare Applicator?
+
What are the key materials?
+
What are the customer survey results?
+